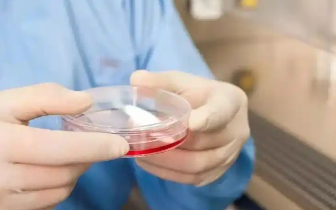
image.png

長(zhǎng)沙干細(xì)胞移植費(fèi)用多少,怎樣查詢(xún)具體價(jià)格明細(xì)
2024-12-10 15:33:03 來(lái)源: 小編 咨詢(xún)醫(yī)生
干細(xì)胞移植作為一種前沿的生物技術(shù),在治療多種疾病方面取得了顯著成效。長(zhǎng)沙作為我國(guó)生物技術(shù)發(fā)展的前沿城市,許多患者關(guān)心當(dāng)?shù)氐母杉?xì)胞移植費(fèi)用問(wèn)題。本文將詳細(xì)介紹長(zhǎng)沙干細(xì)胞移植的費(fèi)用及查詢(xún)價(jià)格明細(xì)的方法。
一、長(zhǎng)沙干細(xì)胞移植費(fèi)用概述
干細(xì)胞移植的費(fèi)用受多種因素影響,包括患者病情、移植類(lèi)型、醫(yī)療機(jī)構(gòu)等級(jí)等。以下是長(zhǎng)沙地區(qū)干細(xì)胞移植費(fèi)用的大致范圍:
1.臍帶血干細(xì)胞移植:費(fèi)用約為10-20萬(wàn)元人民幣;
2.外周血干細(xì)胞移植:費(fèi)用約為15-30萬(wàn)元人民幣;
3.骨髓干細(xì)胞移植:費(fèi)用約為20-40萬(wàn)元人民幣。
需要注意的是,這些費(fèi)用僅供參考,具體價(jià)格還需根據(jù)實(shí)際情況確定。
二、如何查詢(xún)長(zhǎng)沙干細(xì)胞移植具體價(jià)格明細(xì)
1.咨詢(xún)醫(yī)療機(jī)構(gòu)
患者可以直接前往長(zhǎng)沙當(dāng)?shù)氐尼t(yī)療機(jī)構(gòu),如中南大學(xué)湘雅醫(yī)院、湖南省人民醫(yī)院等,向?qū)I(yè)人士咨詢(xún)干細(xì)胞移植的具體費(fèi)用。醫(yī)療機(jī)構(gòu)會(huì)根據(jù)患者的病情、移植類(lèi)型等因素,提供詳細(xì)的價(jià)格明細(xì)。
2.網(wǎng)上查詢(xún)
患者可以通過(guò)以下途徑在網(wǎng)上查詢(xún)長(zhǎng)沙干細(xì)胞移植的價(jià)格明細(xì):
(1)搜索“長(zhǎng)沙干細(xì)胞移植費(fèi)用”關(guān)鍵詞,查看相關(guān)網(wǎng)頁(yè)信息;
(2)登錄醫(yī)療機(jī)構(gòu)官方網(wǎng)站,查看收費(fèi)標(biāo)準(zhǔn);
(3)在醫(yī)療論壇、問(wèn)答平臺(tái)上提問(wèn),獲取網(wǎng)友分享的經(jīng)驗(yàn)。
3.電話咨詢(xún)
患者可以撥打長(zhǎng)沙當(dāng)?shù)蒯t(yī)療機(jī)構(gòu)的電話,向工作人員咨詢(xún)干細(xì)胞移植的費(fèi)用。工作人員會(huì)根據(jù)患者提供的信息,提供詳細(xì)的價(jià)格明細(xì)。
三、注意事項(xiàng)
1.價(jià)格并非唯一標(biāo)準(zhǔn)
在選擇干細(xì)胞移植醫(yī)院時(shí),價(jià)格并非唯一標(biāo)準(zhǔn)?;颊哌€需關(guān)注醫(yī)院的資質(zhì)、技術(shù)水平、成功率等因素,以確保治療的安全性和效果。
2.合理安排治療時(shí)間
干細(xì)胞移植手術(shù)具有一定的風(fēng)險(xiǎn),患者應(yīng)在醫(yī)生的指導(dǎo)下,合理安排治療時(shí)間,避免因病情惡化導(dǎo)致治療費(fèi)用增加。
四、總結(jié)
長(zhǎng)沙干細(xì)胞移植費(fèi)用受多種因素影響,患者可通過(guò)多種途徑查詢(xún)具體價(jià)格明細(xì)。在選擇醫(yī)療機(jī)構(gòu)時(shí),患者應(yīng)綜合考慮價(jià)格、資質(zhì)、技術(shù)水平等因素,確保治療的安全性和效果。隨著生物技術(shù)的不斷發(fā)展,干細(xì)胞移植技術(shù)在未來(lái)的應(yīng)用將更加廣泛,為更多患者帶來(lái)希望。
-
上一頁(yè): 地貧移植干細(xì)胞費(fèi)用多少,有哪些影響因素
- 2024-11-16海南造血干細(xì)胞費(fèi)用多少錢(qián),一針多少
- 2024-08-22間充質(zhì)干細(xì)胞一針多少錢(qián),能維持多久
- 2024-08-07蘋(píng)果干細(xì)胞美容效果,蘋(píng)果干細(xì)胞美容做一次多少錢(qián)
- 2024-11-05鹽城人體干細(xì)胞治療價(jià)格是多少?如何獲取優(yōu)惠價(jià)格?
- 2024-11-11干細(xì)胞一針費(fèi)用多少錢(qián),靠譜嗎
- 2024-11-12自體干細(xì)胞雙移植費(fèi)用大概多少錢(qián)一次
- 2024-09-27干細(xì)胞療法修復(fù)肝臟可靠嗎?哪些醫(yī)院提供此服務(wù)?
- 2024-10-11男性生殖干細(xì)胞研究進(jìn)展到哪一步?有哪些突破性成果?
- 2024-09-04干細(xì)胞再生技術(shù)是什么,干細(xì)胞再生修復(fù)多少錢(qián)
- 2024-09-11日本鮭魚(yú)干細(xì)胞價(jià)格,鮭魚(yú)干細(xì)胞的護(hù)膚功效
- 2024-10-11干細(xì)胞抗衰老真的靠譜嗎?哪些人群適合做?
- 2024-09-01干細(xì)胞治療耳聾方法,附作用原理介紹
- 2024-08-19干細(xì)胞治療脫發(fā)真的嗎,干細(xì)胞治療脫發(fā)新進(jìn)展
- 2024-09-27廣州貝拉國(guó)際慢性醫(yī)療中心
- 2024-08-19干細(xì)胞軟骨修復(fù)過(guò)程,修復(fù)價(jià)格多少
- 2024-09-11日本鮭魚(yú)干細(xì)胞價(jià)格,鮭魚(yú)干細(xì)胞的護(hù)膚功效
- 2024-08-26腸癌的干細(xì)胞療法最新研究成果與臨床應(yīng)用
- 2024-10-02卵巢早衰干細(xì)胞治療效果如何,有哪些疑問(wèn)需注意
